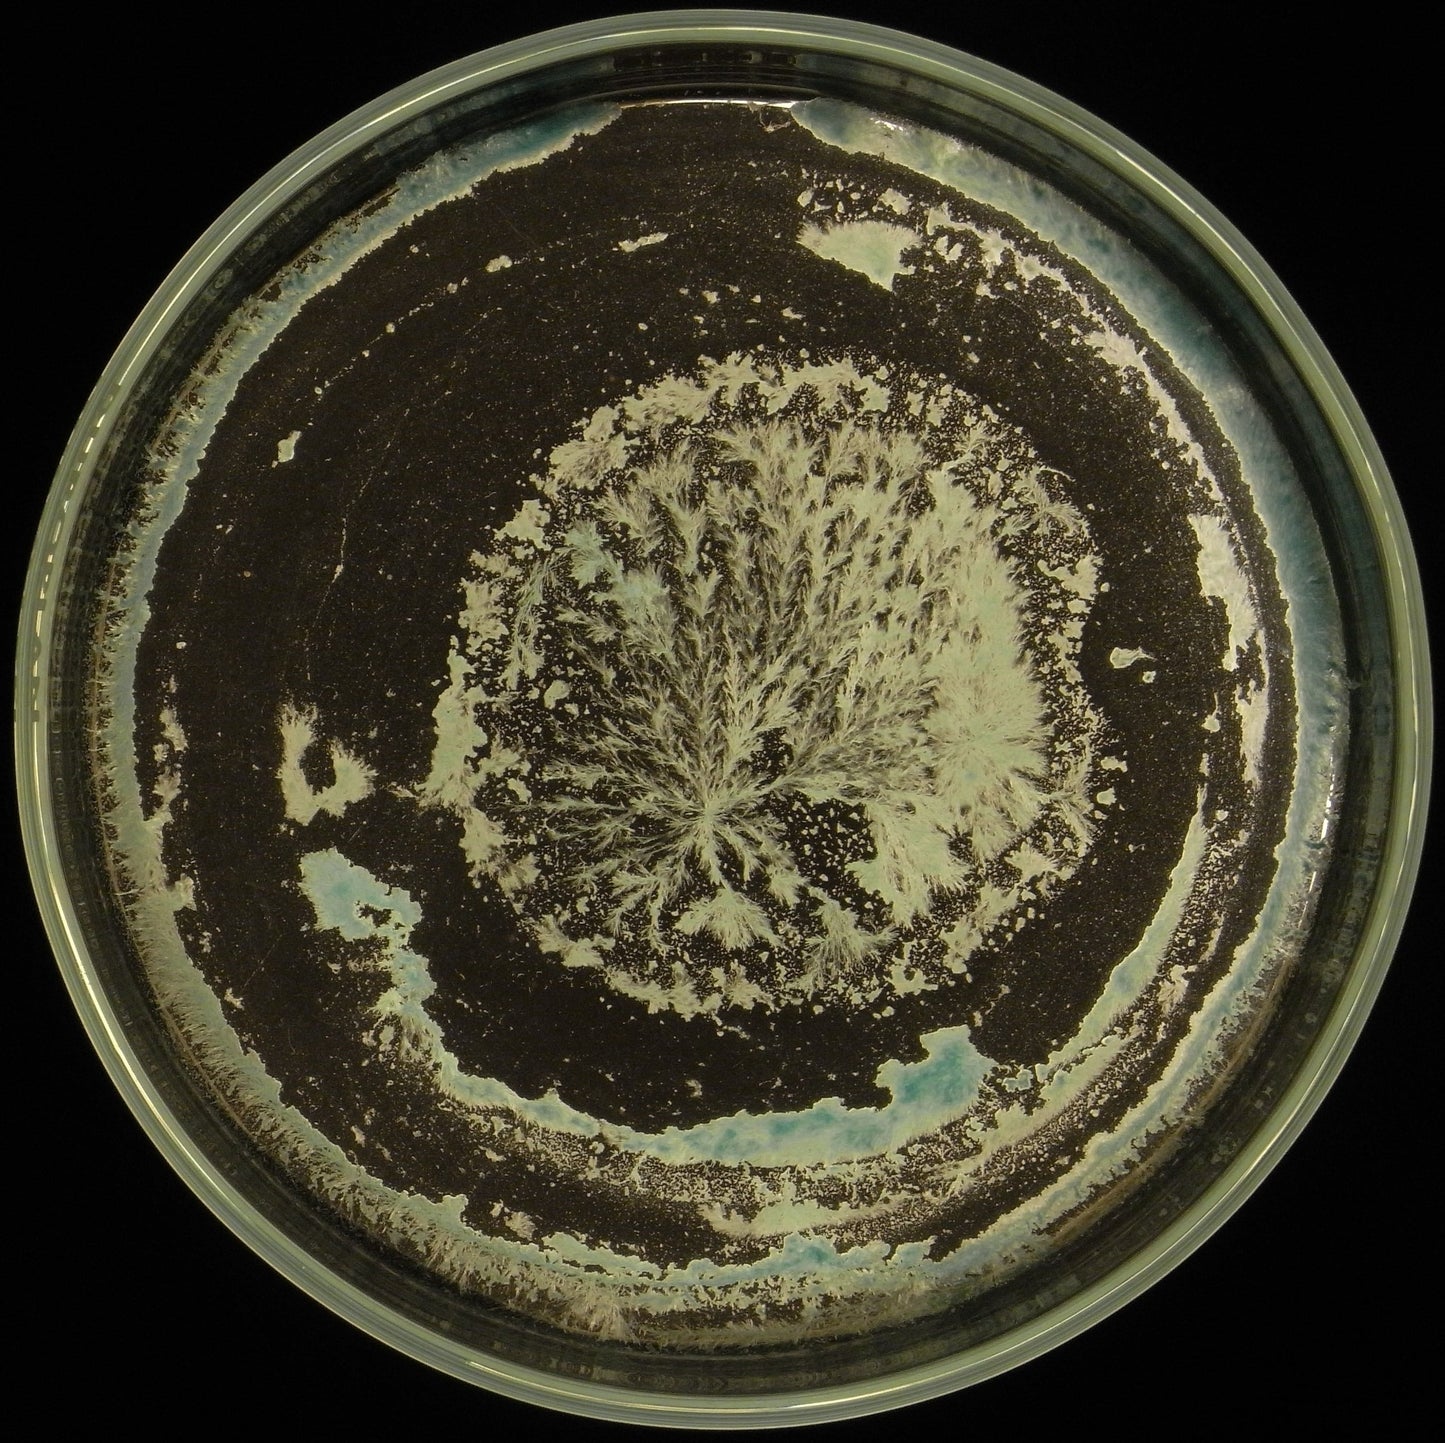

525 CORNO SHUNGITE
Have a question?

525 CORNO SHUNGITE
Dettagli
SCHEDA D'USO 525 CORNO SHUNGITE
Il corno shungite (525) è un preparato biodinamico che è stato a maturare per 18 mesi.
La sunghite è un minerale meteorico che si trova solo nella regione della Karelia (tra Russia e Finlandia) ed ha i fullereni: forme allotropiche di carbonio con C60 e C70
È il solo minerale che contiene tutti gli elementi della scala di Mendelev ed è elettricamente più conduttivo dell’oro, quindi stabilisce contatti e mediazioni con ogni sostanza
Serve per purificare ed addolcire l’acqua, riattiva la percezione cellulare mutilata od inquinata, trasmuta gli elementi che possono danneggiare l’organismo, capta ed inabilita i metalli pesanti, distrugge e trasmuta l’azione dei pesticidi, reidrata il corpo animale, umano e delle piante, ha capacità antibatteriche ed antifungine, disintossica e rafforza le difese immunitarie , aumenta la produzione vegetale.
Si usa, possibilmente, nei giorni centrali del periodo astronomico del Capricorno (19 gennaio – 15 febbraio), il periodo che R. Steiner definisce il più ricettivo della Terra, oppure due giorni prima della Luna Piena, nella settimana dopo Pasqua e quando abbiamo problemi di siccità o attacchi fungini. E’ utile usarlo con Luna in Scorpione od anche nel periodo di Sole in Scorpione.
Usarne 50 grammi per ettaro dinamizzato per 60 minuti in 40-50 litri di acqua e spruzzato al mattino a goccia fine sul terreno.
Presso Agri.Bio trovate due ottime libri che descrivono tutte le qualità della shungite
• Shungite pietra di protezione per eccellenza di Nicolas Almand
• Shungite: energia di vita di Regina Martino
• Vendiamo anche pezzi di shungite